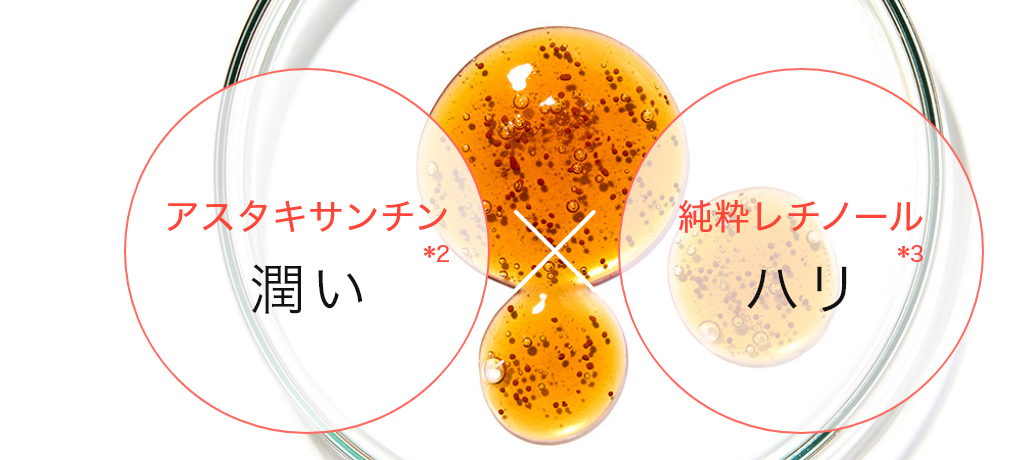

7種の成分で“洗う美容液”
CC1(シーシーワン) フェイスウォッシングモイスト 2本セット
FACE WASHING MOIST 2SET
150g×2〈洗顔料〉
楽天LINE限定初回クーポン
▼クーポンはこちら▼
- ◼︎ 内容量: 150g
- ◼︎ 原産国:日本

DETAILS
汚れを落としながら
7種の成分でエイジングケア
“洗う美容液”
- アスタキサンチン
- 純粋レチノール
- セラミド
- ビタミンA誘導体
- ビタミンE誘導体
- グリセリン
- ビタミンC誘導体
厳選した美容液成分を配合したオールインワン洗顔料。
独自設計のジェルが肌に隅々までいきわたり、 洗い上がりと同時に、肌にうるおいとハリを与えます。
*1 左記の7つの成分のこと *2 年齢に応じたケア *3 (整肌成分) *4 レチノール(整肌成分) *5 セラミドNP、セラミドNG、セラミドAP(保湿、皮膚の保護成分) *6 パルミチン酸レチノール(保湿、整肌成分) *7 酢酸トコフェロール(整肌成分) *8 (保湿、皮膚の保護成分) *9 リン酸アスコルビルMg(整肌成分)
こんな方におすすめ!
-
 ハリがなく小じわが気になってきた
ハリがなく小じわが気になってきた
-
 しっかり保湿しているのに、肌がカサつく
しっかり保湿しているのに、肌がカサつく
-
 ファンデのノリが悪い気がする
ファンデのノリが悪い気がする
-
 夕方のベタつきが気になる
夕方のベタつきが気になる
-
 忙しい朝や疲れた夜は手軽にスキンケアしたい
忙しい朝や疲れた夜は手軽にスキンケアしたい

*1 左記の7つの成分のこと *2 年齢に応じたケア *3 (整肌成分) *4 レチノール(整肌成分) *5 セラミドNP、セラミドNG、セラミドAP(保湿、皮膚の保護成分) *6 パルミチン酸レチノール(保湿、整肌成分) *7 酢酸トコフェロール(整肌成分) *8 (保湿、皮膚の保護成分) *9 リン酸アスコルビルMg(整肌成分)
こんな方におすすめ!
-
 ハリがなく小じわが気になってきた
ハリがなく小じわが気になってきた
-
 しっかり保湿しているのに、肌がカサつく
しっかり保湿しているのに、肌がカサつく
-
 ファンデのノリが悪い気がする
ファンデのノリが悪い気がする
-
 夕方のベタつきが気になる
夕方のベタつきが気になる
-
 忙しい朝や疲れた夜は手軽にスキンケアしたい
忙しい朝や疲れた夜は手軽にスキンケアしたい
POINT
2つのカプセル技術で
酸化することなく肌に届く
マイクロカプセルに包まれた ビタミンA誘導体の液とビタミンE誘導体の液、ナノカプセル包まれたセラミドが“酸化することなく” ハジけて角質層まで浸透。お肌の内側からしっかりうるおいを与えます。
*1 パルミチン酸レチノール(保湿、整肌成分) *2 酢酸トコフェロール(整肌成分) *3 セラミドNP、セラミドNG、セラミドAP(保湿、皮膚の保護成分)

うるおい美容膜によって
閉じ込められた7つの美容成分
美容成分をたっぷり含んだうるおい美容膜が、洗顔中の肌を包み込み、角質層まで浸透。セラミドやビタミンA誘導体、ビタミンE誘導体、アスタキサンチンなど7種の美容成分が、肌にやさしく届けられ、洗いながらエイジングケア 。まるでスキンケアのような洗顔体験を。
*1 DETAILSに記載の7つの成分のこと *2 年齢に応じたケア *3 (整肌成分) *4 レチノール(整肌成分) *5 セラミドNP、セラミドNG、セラミドAP(保湿、皮膚の保護成分) *6 パルミチン酸レチノール(保湿、整肌成分) *7 酢酸トコフェロール(整肌成分) *8 (保湿、皮膚の保護成分) *9 リン酸アスコルビルMg(整肌成分) *10 角質層まで

ハリ×エイジングケア
ピンとしたハリ、
触れたくなる肌へ
アスタキサンチンと純粋レチノールが肌の奥までじゅわっと浸透。ハリ不足の肌にしっかりアプローチ。
年齢サインが気になるお肌に、弾むようなハリとうるおいを与えます。
*1 年齢に応じたケア *2(整肌成分) *3 レチノール(整肌成分) *4 角質層まで
リラックス感たっぷりの
心地良い香りに包まれる
ベルガモットとアプリコットのやわらかな甘さが、ふっと心をほぐしてくれる。
ローズとジャスミンの透明感が肌と気持ちに寄り添い、バニラとアンバー、パチュリの余韻が静かにととのえる。
深呼吸したくなるような、やさしく包み込む香りの洗顔時間を。

成分を守る黒ボトル
天然由来成分のアスタキサンチンは光や酸素に弱く酸化しやすい特徴があります。そこで、遮光性の高い黒ボトルを採用。外部からの光の影響を抑え、酸化を抑制します。
*1 (整肌成分)

HOW TO USE
取り去る・与える・実感する
オールインワン洗顔料
-
STEP1.
初めにぬるま湯で素洗いし、肌のほこりや汚れをとってください。 濡れた手に直径2.5cm程液を出し、少量の水を加えて指全体になじませてください。
-
STEP2.
顔全体にジェルを広げ、なじませるように洗ってください。指を優しく滑らせるように洗うことで肌との摩擦を防ぎながら洗顔できます。
-
STEP3.
少し冷たく感じるくらいのぬるま湯でやさしく擦らずすすいでください。すすぎ残しのないよう念入りに洗い流してください。 柔らかいタオルで肌をおさえるようにして水気をとってください。
FAQ
全成分
水、グリセリン、コカミドプロピルベタイン、ラウロイルメチルアラニンNa、ココイルメチルタウリンNa、アクリレーツコポリマー、ラウレス硫酸Na、レチノール、アスタキサンチン、セラミドNP、セラミドNG、セラミドAP、パルミチン酸レチノール、クエン酸、BG、グアーヒドロキシプロピルトリモニウムクロリド、フェノキシエタノール、ポリソルベート20、PPG-8-セテス-20、ヘマトコッカスプルビアリエキス、水添レシチン、フィトステローズ、キサンタンガム、マンニトール、安息香酸Na、水酸化K、リン酸アスコルビルMg、結晶セルロース、酸化鉄、酢酸トコフェロール、酸化チタン、トリ(カプリル酸/カプリン酸)グリセリル、ヒドロキシプロピルメチルセルロース、香料
ご使用上の注意
-
傷、はれもの、湿疹等異常のあるところには使用しないでください。
-
お肌に異常が生じていないかよく注意して使用してください。化粧品がお肌に合わない時は使用を中止してください。
-
使用中、赤み、はれ、かゆみ、刺激、色抜け(白斑等)や黒ずみ等の異常があらわれた場合や、使用したお肌に直射日光があたって上記のような異常があらわれた場合は、使用中止して、皮フ科医に相談してください。そのまま使用を続けると症状が悪化することがあります。
-
目に入らないように注意してください。入った時はこすらずにすぐに充分洗い流してください。異常が残る場合は眼科医に相談してください。
-
乳幼児や認知症の方などの誤食等を防ぐため置き場所に注意してください。
-
高温または低温の場所や直射日光のあたる場所に置かないでください。










